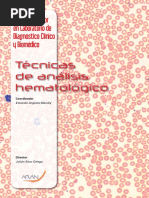

0% encontró este documento útil (0 votos)
74 vistas4 páginasAtividades Gestion Tema 2
El documento describe las funciones de un laboratorio de análisis clínicos. Explica que los avances científicos han causado un aumento en la demanda de pruebas de laboratorio al permitir nuevos análisis más baratos y rápidos. Un laboratorio realiza análisis de muestras biológicas para apoyar diagnósticos médicos, monitorear enfermedades y evaluar tratamientos.
Cargado por
Laura MartinezDerechos de autor
© © All Rights Reserved
Nos tomamos en serio los derechos de los contenidos. Si sospechas que se trata de tu contenido, reclámalo aquí.
Formatos disponibles
Descarga como PDF, TXT o lee en línea desde Scribd
0% encontró este documento útil (0 votos)
74 vistas4 páginasAtividades Gestion Tema 2
El documento describe las funciones de un laboratorio de análisis clínicos. Explica que los avances científicos han causado un aumento en la demanda de pruebas de laboratorio al permitir nuevos análisis más baratos y rápidos. Un laboratorio realiza análisis de muestras biológicas para apoyar diagnósticos médicos, monitorear enfermedades y evaluar tratamientos.
Cargado por
Laura MartinezDerechos de autor
© © All Rights Reserved
Nos tomamos en serio los derechos de los contenidos. Si sospechas que se trata de tu contenido, reclámalo aquí.
Formatos disponibles
Descarga como PDF, TXT o lee en línea desde Scribd